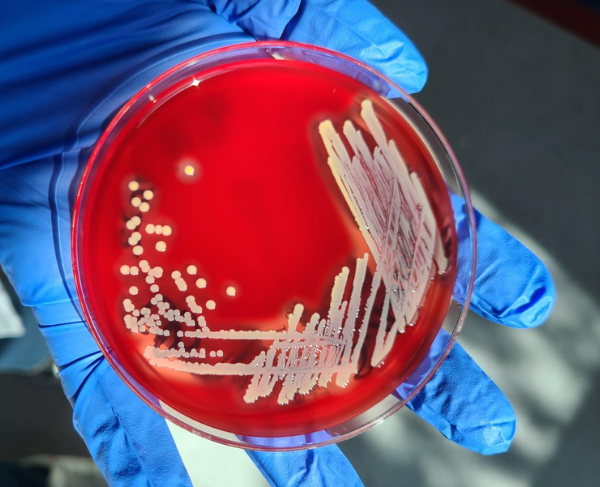

NEWSLETTER
Labskin Insights
We’re delighted to share the very first edition of Labskin Insights.
This inaugural issue provides a behind-the-scenes look at the science, innovation, and growth shaping Labskin today. From advances in microbiome research and skin model development to exciting new collaborations, grant successes, international expansion, and the opening of our new facility in Wetherby, there is plenty to explore.

LATEST NEWS
Long-Distance Shipping of 3D Skin Models
Labskin has partnered with Atelerix to enable reliable, long-distance transport of our advanced in vitro skin models using Atelerix’s non-cryogenic hydrogel technology. This innovation maintains the structural integrity and biological viability of our 3D skin constructs well beyond the traditional 72–96-hour window, allowing for global distribution without compromising quality.
This breakthrough reduces the risks associated with customs delays and cold-chain logistics, helping us expand access to our full-thickness human skin models worldwide.

BBC Feature: Investigating Adult Acne
As one of the leading companies in the field of skin testing, Labskin Ltd was recently contacted by the BBC to assist them with a feature they wanted to do on adult acne.

LATEST PUBLICATIONS
EFFECTs of anti-acne products on microbiota
Labskin Limited is proud to be featured in Personal Care magazine with a case study exploring the effects of anti-acne products on the skin microbiome using Labskin-S. Led by Dr Nicola Kingswell, the study highlights how different products can reduce acne bacteria while balancing inflammation, providing valuable insights for microbiome-informed skincare development.

Using a full thickness bioengineered human skin equivalent as a model for radiation biology research
We’re proud to see Labskin’s human skin equivalent model applied in cutting-edge radiation biology research. A recent open-access article in Scientific Reports describes how a bioengineered full-thickness skin equivalent, colonised with a natural mixed human microbiome, was used to examine molecular and microbial responses to x-ray exposure over extended time periods. The results demonstrate that the Labskin model remains viable, structurally stable, and functionally relevant—even under radiation stress—making it a powerful platform for biodosimetry, radiobiology, and therapeutic development.

LATEST RESEARCH ARTICLE
SARS-CoV-2 survival on skin and its transfer from contaminated surfaces
The Liverpool School of Tropical Medicine, in collaboration with Unilever, recently published a study exploring how SARS-CoV-2 survives on skin and transfers from contaminated surfaces. We’re proud to say they used the Labskin model to make it possible.
This research highlights how Labskin can be applied to virology, infection control, and beyond — offering scientists a reproducible, ethical, and microbiome-ready alternative to human testing.

LATEST BLOG
Top 10 Problems Skin Researchers Face
From ethical concerns to the complexities of replicating human skin conditions, researchers are constantly searching for innovative, reliable, and ethical solutions. Here we explore the top 10 challenges faced by skin researchers and how Labskin can provide the answers.

LATEST BLOG
Five Trends That Will Shape the Future of Healthy Skin Ageing
The skincare industry is moving beyond traditional anti-ageing. Following the 10th Anti-Ageing Skin Care Conference, Nicola Kingswell, Scientific Director, and Holly Lyons, Client Project Manager at LabSkin, share the five trends they believe will have the biggest impact on product development, testing and consumer expectations in the years ahead.

INTERVIEW
Why Labskin-S Was the
Model of Choice for
SARS-CoV-2 Skin Studies
Discover the latest advances in viral transmission research with this in-depth report from Labskin. It explores innovative laboratory models and methods that are helping scientists better understand how viruses spread, offering valuable insights for drug development and public health.

LATEST POSTER
Labskin full thickness with A375 melanoma cells as a medium to study Melanoma
This poster presents LabSkin’s latest work using our 3D full-thickness skin equivalent as a platform to study melanoma progression. Built on a fibrin gel, LabSkin incorporates human dermal adult fibroblasts (HDFa) and human epidermal neonatal keratinocytes (HEKn) cultured through a staged process to recreate a physiologically relevant skin environment. To model melanoma, A375 spheroid clusters (up to 1 × 10⁵ cells) are formed in Haem-coated plates and integrated into LabSkin prior to keratinocyte seeding. This approach enables researchers to investigate melanoma behaviour within a controlled, tissue-realistic system, supporting more predictive and ethical preclinical testing.

LATEST RESEARCH
White Papers

AN INTRODUCTION TO THE SCALP MICROBIOME
Analysis of the scalp microbiome and the microbiota that colonise this ecosystem is growing rapidly.

THE SCIENCE BEHIND SKIN MICROBIOME IN HEALTH AND DISEASE
Discover why the skin microbiome is reshaping the skincare industry and how you can harness this knowledge to develop products that truly make a difference.

WHAT SHAMPOO INGREDIENTS REALLY DO TO YOUR SCALP MICROBIOME
Discover how shampoo ingredients influence the scalp microbiome using Labskin’s simplified 3D skin model, revealing more human-relevant insights into formulation impact and scalp health.

ACNE DEMOGRAPHICS AND MICROBIOME INSIGHTS
This whitepaper examines global acne trends and the role of the skin microbiome, revealing how microbiome-driven insights are transforming acne research and skincare innovation.
A FULL-THICKNESS 3D SKIN MODEL FOR ATOPIC DERMATITIS
LabSkin-AD is a physiologically relevant human in vitro model of atopic dermatitis that replicates key structural, inflammatory and microbiome features of the disease while enabling robust therapeutic testing and mechanistic insight.

AN INTRODUCTION TO THE VAGINAL MICROBIOME
Research into the vaginal microbiome and how it affects the overall health of women has accelerated over the last decade.
POSTERS
Colonisation of a 3D Skin Model
2018 L’Occitane 3D Skin Model Complete Microbiota is more beneficial to skin barrier than Staphylococcus Epidermidis Alone
Drug Absorption in Living Skin
2017 Detection of drug absorption in living skin equivalent models by using MALDI-MSI
Non-invasive biodosimetry: space applications of skin swabs-based omics.
2017 Proteomics and Substrate Based MS Imaging of Xenobiotic Metabolising Enzymes in ex Vivo Human Skin and a Human Living Skin Equivalent Model
2015 MALDI-MSI for the analysis of a 3D tissue-engineered psoriatic skin model
2013 In vitro screening of a human skin equivalent model
Published Papers
Challenges Developing a Human Model System for Skin Microbiome Research
The human skin is colonised by a diversity of microorganisms. The human skin microbiome has come into great interest for its role in skin health and disease, and as a potential target for therapeutic and cosmetic applications (Byrd et al. 2018). A major limitation in the laboratory investigation of microbial and host-microbe interactions on human skin is the lack of a model that can reliably reproduce the complexity of the host. Attempts to model human microbial communities in rodents are impeded by competition from native flora, and even germ-free models suffer due to the substantial differences between murine and human integumentary systems.
VIEW →
MDPI – 2017 Non-Invasive Assessment of Skin Barrier Properties
Investigating Emerging Tools for In Vitro and In Vivo Applications.
There is increasing interest in the development of non-invasive tools for studying the properties of skin, due to the potential for non-destructive sampling, reduced ethical concerns and the potential comparability of results in vivo and in vitro.
VIEW →
L’Occitane – Colonization of a 3D Skin Model
3D skin models are getting closer to the reality of cutaneous physiology. They can include multiple cell types, from healthy or pathological skin or be submitted to various stresses mimicking the skin’s environment.
VIEW →
International Journal of Cosmetic Science – 2018 Examination of the Skin Barrier Repair Wound Healing Process
Damage to the structural integrity of the skin through trauma or injury initiates the skin barrier repair/wound healing process, which is highly complex and carefully regulated with ordered responses. There are four main stages involved in the normal skin barrier repair/wound healing process: haemostasis, inflammation, proliferation and remodelling, all of which occur in an over-lapping chronological sequence.
VIEW →
Journal of Antimicrobial Chemotherapy – Redox-active Compounds With A History Of Human Use
To investigate the antistaphylococcal/antibiofilm activity and mode of action (MOA) of a panel of redoxactive (RA) compounds with a history of human use and to provide a preliminary preclinical assessment of their potential for topical treatment of staphylococcal infections, including those involving a biofilm component.
VIEW →
Technology Review – Studying the Human Skin Microbiome Using 3D In Vitro Skin Models
Three-dimensional(3D)human skin models are an accepted part of the testing and regulatory landscape in skin related industries and their development, commercialisation, and uses have been well documented. At present, there are several established commercial model systems and a multitude of academic lab-specific 3D in vitro reconstructed human skin models, all with different characteristics, strengths, and weaknesses.
VIEW →
Analytical Chemistry – Curcumin A Multipurpose Matrix for MALDI Mass Spectrometry Imaging Applications
Turmeric (Curcuma longa) is a rhizomatous herbaceous plant belonging to the ginger family Zingiberaceae. The main components of tumeric are 1,7-bis-(4-hydroxy-3-methoxy-phenyl)-hepta-1,6-diene-3,5-dione (also known as curcumin),which can exist in keto and enol forms (tautomers), and its desmethoxy and bis-desmethoxy derivatives which are present in varying ratios.
VIEW →
University of Leeds – Immune Responses of a Living Skin Equivalent Model Colonized by Staphylococcus Epidermidis or Staphylococcus Aureus
Biofilms comprise structured communities of microorganisms in a self-produced extracellular matrix, usually attached to an organic or abiotic surface.
VIEW →
An aqueous watercress extract with topical anti-inflammatory properties in inflamed human skin
This new publication, co-authored by our Microbiology Services Manager Bart Cwkla, showcases how the Labskin model was used to demonstrate the anti-inflammatory potential of watercress extract. The study highlights Labskin’s value in delivering reliable, human-relevant insights for skin research.
Protoemics Journal – 2018 Mass Spectrometry Imaging of 3D Tissue Models
A 3D cell culture is an artificially created environment in which cells are permitted to grow/interact with their surroundings in all three dimensions. Derived from 3D cell culture, organoids are generally small-scale constructs of cells that are fabricated in the laboratory to serve as 3D representations of in vivo tissues and organs.
VIEW →
Elsevier Journal – Lipid Changes in Living Skin Equivalents in Response to Creams Containing Palmitoylethanolamide
Whilst many immunohistochemistry, autoradiography and spectroscopic methods are routinely used in dermatological research, the application of MALDI MSI is still relatively new. One of the key features of MALDI MSI that makes its use appealing is the ability to detect and study the distribution of multiple compounds simultaneously in a label-free manner.
VIEW →
Journal of Antimicrobial Chemotherapy – 2016 Tert-butyl Benzoquinone Mechanism of Biofilm Eradication
Biofilms comprise structured communities of microorganisms in a self-produced extracellular matrix, usually attached to an organic or abiotic surface.
For many bacteria, including a substantial proportion of those that cause human disease, the biofilm represents the usual mode of growth. Infections involving a substantial biofilm component (e.g. chronic wounds) are notoriously difficult to treat; not only does the physiological status of the bacteria inside the biofilm render them refractory to killing by extant anti bacterial drugs, but the extracellular matrix acts to physically shield the inhabitants from attack by the host’s immune system. One approach to address the current difficulties we face in treating bio-film infections is to discover new antibacterial agents that demonstrate substantial killing and or eradication of bacterial biofilms.
VIEW →
Lipids In Health and Disease – Lipid Changes Within The Epidermis Of Living Skin Equivalents
Mass spectrometry imaging (MSI) is a powerful tool for the study of intact tissue sections. Here, its application to the study of the distribution of lipids in sections of reconstructed living skin equivalents during their development and maturation is described.
VIEW →
Evocutis – 3D Living Skin Models For Product Development
Testing personal care products using clinical trials is the gold standard for proving efficacy, but is often seen as too expensive to be considered cost-effective. However, formal proof that a product works is highly motivating to consumers, as demonstrated by the runaway success of Boots Protect & Perfect anti-ageing serum in 2009.
VIEW →
University of Leeds – Microbial Colonization of an In Vitro Model of a Tissue-Engineered Human Skin Equivalent
This was a preliminary investigation to define the conditions of colonization of a human skin equivalent (SE) model with cutaneous microorganisms.
SEs of 24 mm diameter were constructed with a dermal matrix of fibrin containing fibroblasts and a stratified epidermis. Microbial colonisation of the SEs was carried out in a dry environment, comparable to ‘in vivo’ skin, using a blotting technique to remove inoculation fluid. The microbial communities were sampled by scrub washing and viable cells were enumerated on selective growth medium.
VIEW →
Effect of commonly used cosmetic preservatives on skin resident microflora dynamics
This study explores how everyday cosmetic preservatives influence the natural microbial communities living on human skin. Using Labskin’s advanced 3D living skin model, researchers were able to track changes in the skin microbiome over time, providing valuable insights into how products interact with skin-resident microbes. The findings highlight the importance of considering microbial dynamics when formulating skincare products, ensuring they maintain a healthy skin ecosystem.
VIEW →
Direct identification of bacterial and human proteins from infected wounds in living 3D skin models
In this research, Labskin’s living 3D skin model was used to study protein interactions in infected wounds, enabling direct identification of both bacterial and human proteins. This approach provides a more realistic understanding of wound infections and the molecular responses of skin to microbial invasion. The study demonstrates the power of Labskin models for investigating complex skin biology and developing better strategies for wound care.
VIEW →
Publications
Iliopoulos F, Chapman A, Lane ME.Int J Cosmet Sci. 2021 Feb;43(1):107-112. doi: 10.1111/ics.12675. Epub 2020 Dec 25.PMID: 33238056
Couto N, Newton JRA, Russo C, Karunakaran E, Achour B, Al-Majdoub ZM, Sidaway J, Rostami-Hodjegan A, Clench MR, Barber J.Drug Metab Dispos. 2021 Jan;49(1):39-52. doi: 10.1124/dmd.120.000168. Epub 2020 Nov 2.PMID: 33139459
SARS-CoV-2 survival on skin and its transfer from contaminated surfaces.
Pitol AK, Venkatesan S, Richards S, Hoptroff M, Majumdar A, Hughes GL.PLoS One. 2025 Jun 20;20(6):e0325235. doi: 10.1371/journal.pone.0325235. eCollection 2025.PMID: 40540458 Free PMC article.
MALDI-MSI for the analysis of a 3D tissue-engineered psoriatic skin model.
Harvey A, Cole LM, Day R, Bartlett M, Warwick J, Bojar R, Smith D, Cross N, Clench MR.Proteomics. 2016 Jun;16(11-12):1718-25. doi: 10.1002/pmic.201600036.PMID: 27226230 Free PMC article.
Challenges in Developing a Human Model System for Skin Microbiome Research.
Larson PJ, Chong D, Fleming E, Oh J.J Invest Dermatol. 2021 Jan;141(1):228-231.e4. doi: 10.1016/j.jid.2020.05.096. Epub 2020 Jun 6.PMID: 32522484 Free PMC article. Review. No abstract available.
Wallace RG, Kenealy MR, Brady AJ, Twomey L, Duffy E, Degryse B, Caballero-Lima D, Moyna NM, Custaud MA, Meade-Murphy G, Morrin A, Murphy RP.Burns. 2020 Nov;46(7):1585-1602. doi: 10.1016/j.burns.2020.04.036. Epub 2020 May 14.PMID: 32475797 Free article.
Do Melanocytes Have a Role in Controlling Epidermal Bacterial Colonisation and the Skin Microbiome?
Bi O, Caballero-Lima D, Sikkink S, Westgate G, Kauser S, Elies J, Thornton MJ.Exp Dermatol. 2025 Mar;34(3):e70071. doi: 10.1111/exd.70071.PMID: 40051134 Free PMC article.
TALK TO A LABSKIN EXPERT TODAY
Ready to start your next project? A member of the Labskin team can tell you more about our unique full-thickness human skin model and validated testing platform.
